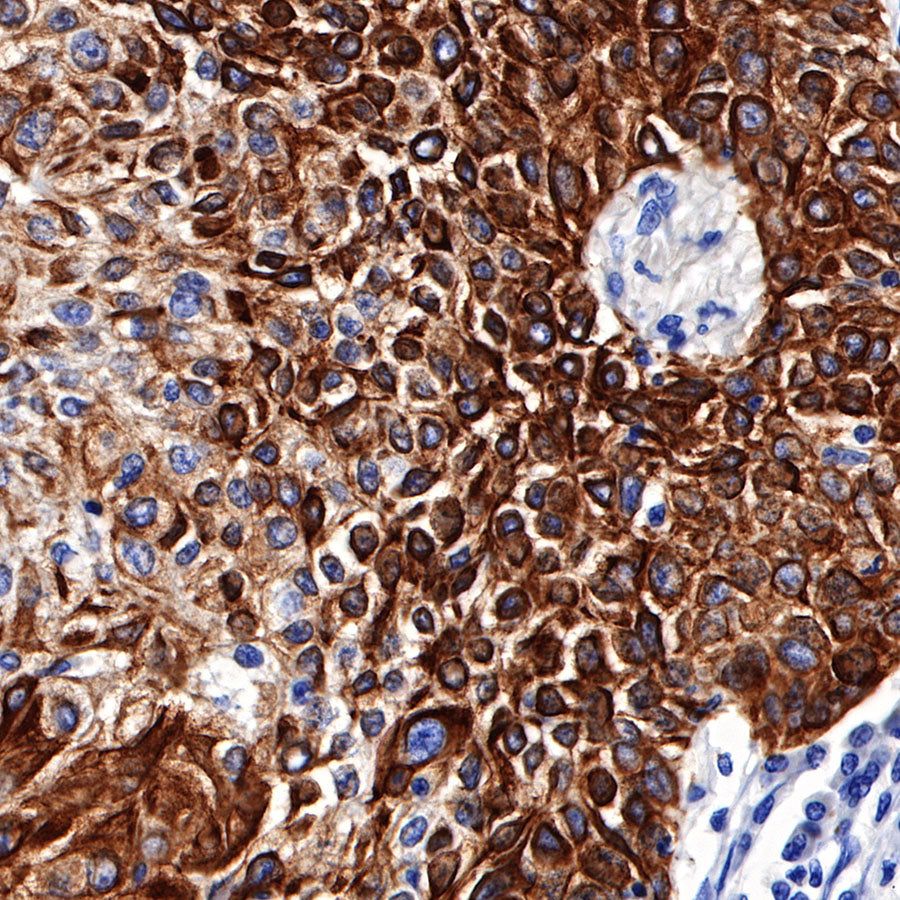
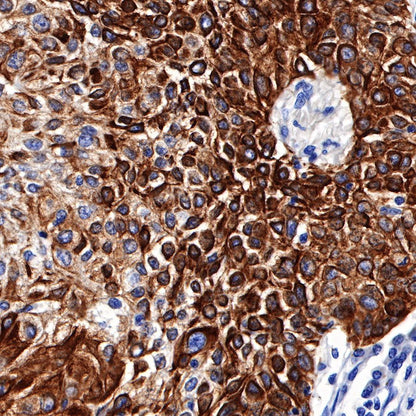

WB result of CK5/6 Rabbit mAb
Primary antibody: CK5/6 Rabbit mAb at 1/5000 dilution
Lane 1: A431 whole cell lysate 20 µg
Secondary antibody: Goat Anti-Rabbit IgG, (H+L), HRP conjugated at 1/10000 dilution
Predicted MW: 56, 58 kDa
Observed MW: 56, 58 kDa
Exposure time: 5s
Product Details
Product Details
Product Specification
| Host | Rabbit |
| Antigen | CK5/6 |
| Synonyms | Keratin 5/6, Cytokeratin 5/6 |
| Immunogen | N/A |
| Location | Cytoplasm |
| Clone Number | SDT-P004 |
| Antibody Type | Rabbit mAb |
| Application | WB, IHC-P, IF |
| Reactivity | Hu |
| Purification | Protein A |
| Concentration | 0.2 mg/ml |
| Physical Appearance | Liquid |
| Storage Buffer | PBS, 40% Glycerol, 0.05% BSA, 0.03% Proclin 300 |
| Stability & Storage | 12 months from date of receipt / reconstitution, -20 °C as supplied |
Dilution
| application | dilution | species |
| IHC-P | 1:1000 | |
| WB | 1:5000 | |
| IF | 1:500 |
Background
The molecular weights of CK5/6 (Cytokeratin 5/6) are 56kDa and 58kDa. Expressed in basal and stratum spinosum of the skin, as well as in the prostate basal cells and squamous epithelial cells. It can be used for the differential diagnosis of squamous cell carcinoma and adenocarcinoma, as well as mesothelioma and adenocarcinoma. It combined with p63 and AMACR/p504s for diagnosis of benign and malignant prostatic lesions.
Picture
Picture
Western Blot

Immunohistochemistry

IHC shows positive staining in paraffin-embedded human tonsil. Anti-CK5/6 antibody was used at 1/1000 dilution, followed by a HRP Polymer for Mouse & Rabbit IgG (ready to use). Counterstained with hematoxylin. Heat mediated antigen retrieval with Tris/EDTA buffer pH9.0 was performed before commencing with IHC staining protocol.
(This IHC was developed using Immuno-Histo Stainer: PA-3600.)

IHC shows positive staining in paraffin-embedded human prostatic hyperplasia. Anti-CK5/6 antibody was used at 1/1000 dilution, followed by a HRP Polymer for Mouse & Rabbit IgG (ready to use). Counterstained with hematoxylin. Heat mediated antigen retrieval with Tris/EDTA buffer pH9.0 was performed before commencing with IHC staining protocol.
(This IHC was developed using Immuno-Histo Stainer: PA-3600.)

IHC shows positive staining in paraffin-embedded human breast invasive ductal carcinoma. Anti-CK5/6 antibody was used at 1/1000 dilution, followed by a HRP Polymer for Mouse & Rabbit IgG (ready to use). Counterstained with hematoxylin. Heat mediated antigen retrieval with Tris/EDTA buffer pH9.0 was performed before commencing with IHC staining protocol.
(This IHC was developed using Immuno-Histo Stainer: PA-3600.)

IHC shows positive staining in paraffin-embedded human cervical squamous cell carcinoma. Anti-CK5/6 antibody was used at 1/1000 dilution, followed by a HRP Polymer for Mouse & Rabbit IgG (ready to use). Counterstained with hematoxylin. Heat mediated antigen retrieval with Tris/EDTA buffer pH9.0 was performed before commencing with IHC staining protocol.
(This IHC was developed using Immuno-Histo Stainer: PA-3600.)

IHC shows positive staining in paraffin-embedded human lung squamous cell carcinoma. Anti-CK5/6 antibody was used at 1/1000 dilution, followed by a HRP Polymer for Mouse & Rabbit IgG (ready to use). Counterstained with hematoxylin. Heat mediated antigen retrieval with Tris/EDTA buffer pH9.0 was performed before commencing with IHC staining protocol.
(This IHC was developed using Immuno-Histo Stainer: PA-3600.)

Negative control: IHC shows negative staining in paraffin-embedded human hepatocellular carcinoma. Anti-CK5/6 antibody was used at 1/1000 dilution, followed by a HRP Polymer for Mouse & Rabbit IgG (ready to use). Counterstained with hematoxylin. Heat mediated antigen retrieval with Tris/EDTA buffer pH9.0 was performed before commencing with IHC staining protocol.
(This IHC was developed using Immuno-Histo Stainer: PA-3600.)
Immunofluorescence

IF shows positive staining in paraffin-embedded human tonsil. Anti-CK5/6 antibody was used at 1/500 dilution (magenta) and incubated overnight at 4°C. Goat polyclonal Antibody to Rabbit IgG - H&L (Alexa Fluor® 647) was used as secondary antibody at 1/500 dilution. Counterstained with DAPI (Blue). Heat mediated antigen retrieval with EDTA buffer pH9.0 was performed before commencing with IF staining protocol.

IF shows positive staining in paraffin-embedded human prostate. Anti-CK5/6 antibody was used at 1/500 dilution (magenta) and incubated overnight at 4°C. Goat polyclonal Antibody to Rabbit IgG - H&L (Alexa Fluor® 647) was used as secondary antibody at 1/500 dilution. Counterstained with DAPI (Blue). Heat mediated antigen retrieval with EDTA buffer pH9.0 was performed before commencing with IF staining protocol.